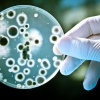
토양·하천 오염하는 항생물질, 세균으로 없앤다고?

-
“1000만 반려인 잡아라” 반려동물 공약 봇물
2018-06-02 서울신문 -
국립백두대간수목원 인기몰이?방문객 구름 인파
2018-06-01 서울Pn -

봄 끝에서 만난 아주 오래된 정원
2018-05-31 서울신문 -

부산항 수입 대나무에서 붉은불개미 발견
2018-05-30 서울신문 -

강아지와 앵무새, 사랑에 빠지다?!
2018-05-30 서울신문 -

‘바퀴벌레 우유’ 한 잔 드실래요?…미래 슈퍼푸드 떠올라
2018-05-28 나우뉴스 -
![[윤기자의 콕 찍어주는 그곳] 액운(厄運)을 물리쳐라 - 경산 삽살개 재단](https://imgnn.seoul.co.kr/img/upload/2018/05/24/SSI_20180524095001_S.jpg)
[윤기자의 콕 찍어주는 그곳] 액운(厄運)을 물리쳐라 - 경산 삽살개 재단
2018-05-24 나우뉴스 -

47년 만에 박제되어 해후한 ‘황새 부부’
2018-05-24 서울신문 -

“작년 여름 이후 묵혔던 에어컨…가동 전 꼭 청소해야”
2018-05-21 서울신문 -
[핵잼 사이언스] 유전자 가위로 카카오나무 질병 유전자 ‘싹둑’
2018-05-19 서울신문 -

15년간 수영장 내 세균 감염자 3만명 (美 CDC)
2018-05-18 나우뉴스 -
“천연기념물 흑고니 돌볼 동물원 찾아요”
2018-05-17 서울Pn -
![[와우! 과학] 유전자 가위 이용한 ‘슈퍼 초콜릿’ 나온다](https://imgnn.seoul.co.kr/img/upload/2018/05/11/SSI_20180511135609_S.jpg)
[와우! 과학] 유전자 가위 이용한 ‘슈퍼 초콜릿’ 나온다
2018-05-11 나우뉴스 -
![[여기는 남미] 인간 탓에…아마존 돌고래 멸종 위기](https://imgnn.seoul.co.kr/img/upload/2018/05/04/SSI_20180504092055_S.jpg)
[여기는 남미] 인간 탓에…아마존 돌고래 멸종 위기
2018-05-04 나우뉴스 -
토양·하천 오염하는 항생물질, 세균으로 없앤다고?
2018-05-01 나우뉴스 -
클렌징 디바이스 ‘포레오(FOREO), ON STYLE ‘겟 잇 뷰티’에 소개돼 눈길
2018-04-27 나우뉴스 -
![[이소영의 도시식물 탐색] 향기로 식물을 느껴 보세요](https://img.seoul.co.kr/img/upload/2018/04/25/SSI_20180425182902_S.jpg)
[이소영의 도시식물 탐색] 향기로 식물을 느껴 보세요
2018-04-26 서울신문 -

“개나 고양이처럼 바라봐 주세요” 털 없는 귀요미 사랑꾼
2018-04-24 서울신문 -
![[여기는 중국] 한해 60억 마리 바퀴벌레 생산하는 中농장](https://imgnn.seoul.co.kr/img/upload/2018/04/19/SSI_20180419135841_S.jpg)
[여기는 중국] 한해 60억 마리 바퀴벌레 생산하는 中농장
2018-04-19 나우뉴스 -
![[책꽂이]](https://img.seoul.co.kr/img/upload/2018/04/13/SSI_20180413175602_S.jpg)
[책꽂이]
2018-04-14 서울신문 -
![[와우! 과학] 뇌세포 없는 박테리아, 자손에게 기억 물려준다](https://imgnn.seoul.co.kr/img/upload/2018/04/10/SSI_20180410131956_S.jpg)
[와우! 과학] 뇌세포 없는 박테리아, 자손에게 기억 물려준다
2018-04-10 나우뉴스 -

강제권 없는 동물단체, “학대견 몰래 데려오기도…”
2018-04-03 서울신문 -

필수 아이템‘황사 마스크’, 싸게 구입하려면?
2018-03-29 서울신문 -
![[이소영의 도시식물 탐색] 봄꽃 개나리의 비애](https://img.seoul.co.kr/img/upload/2018/03/28/SSI_20180328154004_S.jpg)
[이소영의 도시식물 탐색] 봄꽃 개나리의 비애
2018-03-29 서울신문 -

“물 닿은 목욕 장난감, 세균 최대 7500만 마리 번식”(연구)
2018-03-28 나우뉴스 -
![[다이노+] 트리케라톱스 등 각룡류 뿔 진화 “짝짓기 목적”](https://imgnn.seoul.co.kr/img/upload/2018/03/25/SSI_20180325113021_S.jpg)
[다이노+] 트리케라톱스 등 각룡류 뿔 진화 “짝짓기 목적”
2018-03-25 나우뉴스 -

번식 위해 합사한 시베리아호랑이에 암컷 물려 죽어
2018-03-24 서울신문 -
![[와우! 과학] 바퀴벌레의 극강 생존력 비밀…DNA에서 찾았다](https://imgnn.seoul.co.kr/img/upload/2018/03/22/SSI_20180322103308_S.jpg)
[와우! 과학] 바퀴벌레의 극강 생존력 비밀…DNA에서 찾았다
2018-03-22 나우뉴스 -

“이제 9개월 됐어요” 세상에서 가장 큰 ‘키 180㎝ 강아지’
2018-03-19 나우뉴스 -
![[이소영의 도시식물 탐색] 쑥, 잡초와 약용식물 사이에서](https://img.seoul.co.kr/img/upload/2018/03/14/SSI_20180314175618_S.jpg)
[이소영의 도시식물 탐색] 쑥, 잡초와 약용식물 사이에서
2018-03-15 서울신문


